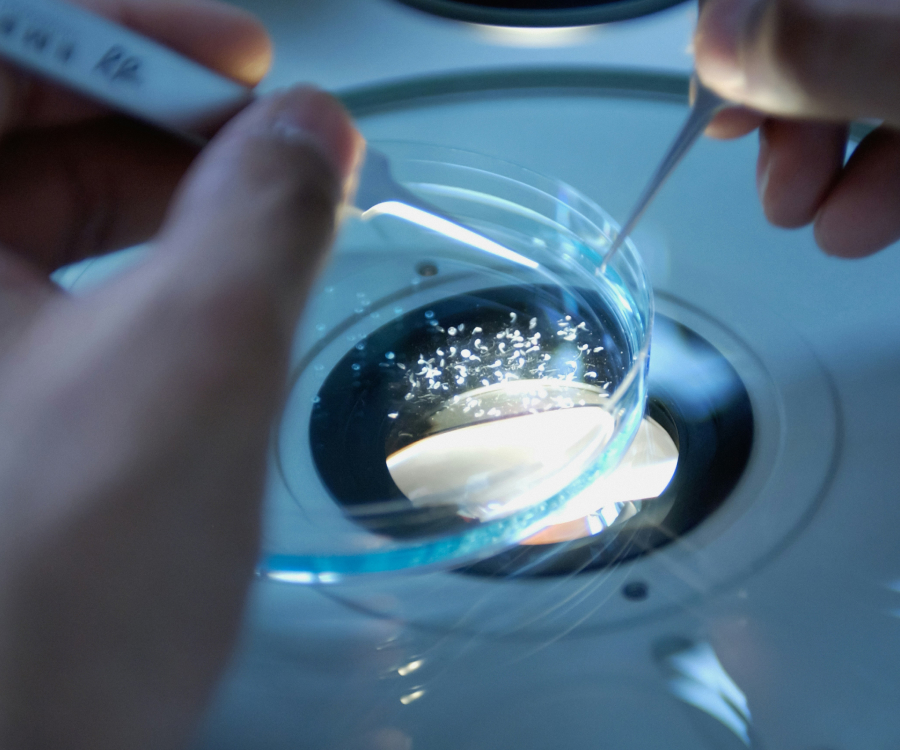
Santander Open Academy

Para
Negocios/Pymes
Startups/Scaleups
Ofrecido por AROSA I+D
Negocios/Pymes
Startups/Scaleups
España
Disponible
Registrarte y dar de alta tu empresa en Santander X
Servicios de fiscalidad y financiación pública personalizados. Descubre nuestra oferta de servicios de asesoramiento, búsqueda de financiación pública e incentivos I+D+i y activación de diferentes palancas de ahorro.
Desde ClarkeModet te ofrecemos acceso a servicios de fiscalidad y financiación pública especializada a través de nuestra empresa AROSA I+D.
Descubre qué es lo que mejor se adapta a tu empresa con nuestros servicios de asesoramiento, búsqueda de financiación pública e incentivos I+D+i y activación de diferentes palancas de ahorro: deducciones fiscales, bonificaciones por personal investigador, sello pyme innovadora, certificado de empresa emergente, patent box, tax-lease, rondas de inversión con inversores privados y ayudas a la mejora de la eficiencia energética.
Podrás contar con un roadmap de acompañamiento que te ayudará a cumplir los presupuestos de tus proyectos de I+D+i, realizando una correcta estrategia de optimización.
Por ser miembro de Santander X, tienes acceso a un descuento del 10% en los servicios que te ofrecemos.
¡Aprovéchate de los beneficios y ventajas que tiene ser miembro de Santander X!
No, al beneficio o descuento accederá quien registre la empresa
No hay ningún requisito técnico asociado, aunque te recomendamos que acceder a través de un ordenador y con una buena conexión a internet.
Cuando te hayas registrado y hayas dado de alta tu empresa, podrás acceder al enlace o código y las instrucciones de canjeo a realizar en la web del partner.
Dependerá de las condiciones de canjeo que establezca cada partner. En el email que recibirás cuando lo canjees se detallarán.
En esta sección te ofrecemos los mejores recursos con grandes descuentos para tu negocio.
No, están segmentados por tipo de negocio/empresa.
Los beneficios y los servicios o recursos a que se refieren se ofrecen exclusivamente por terceros, no por Banco Santander, que no asume responsabilidad en relación con los mismos. La contratación efectiva del beneficio se realiza directamente en el sitio web del tercero. Banco Santander se limita a publicar los beneficios con un carácter publicitario.